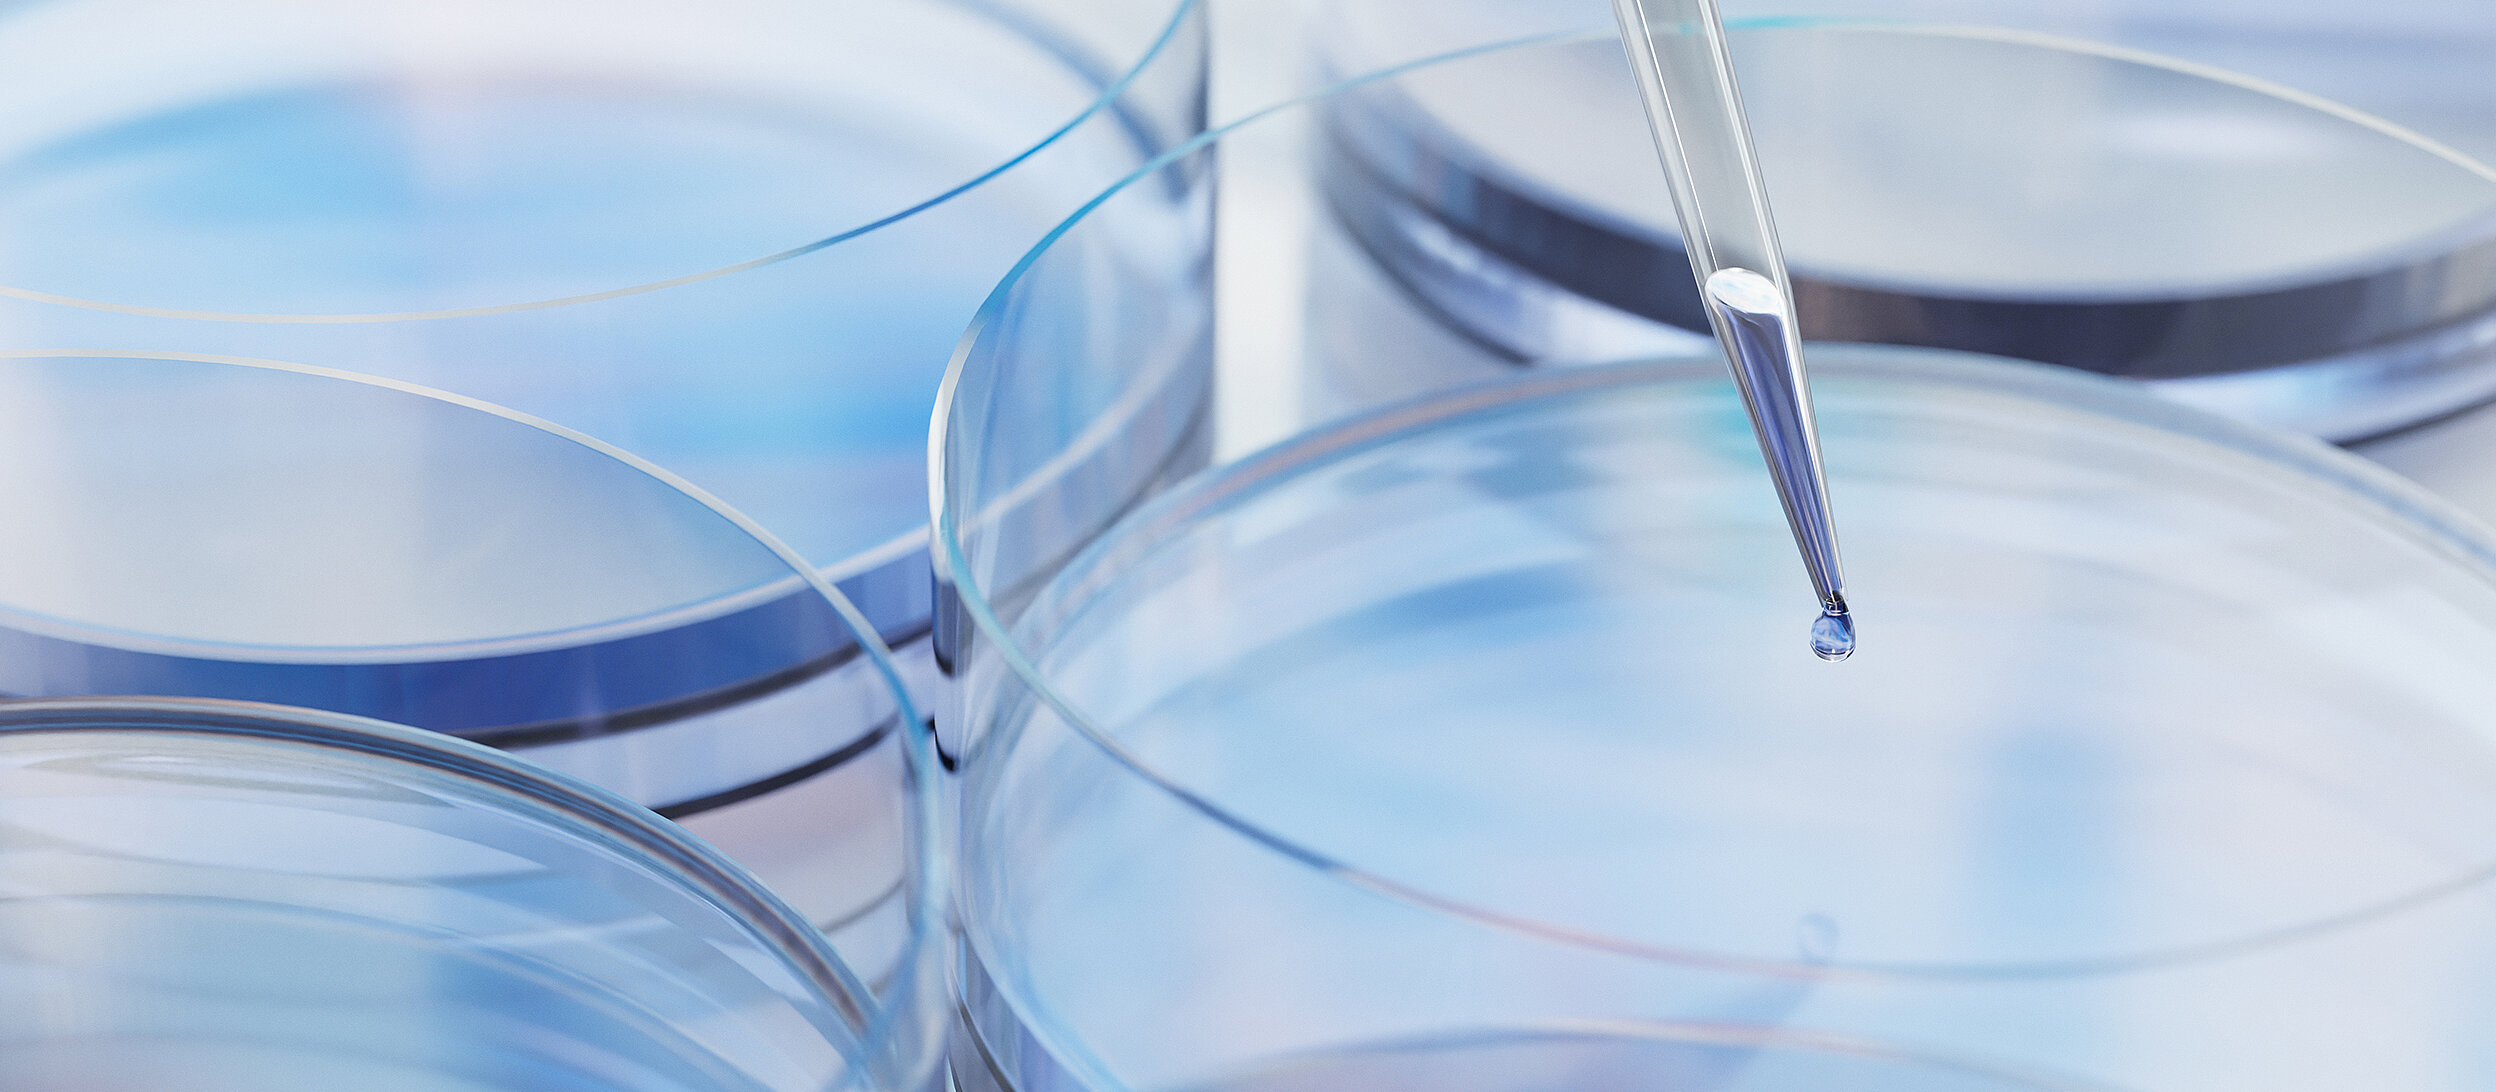

Ist medizinisches Cannabis in Deutschland legal?
Seit 2017 kann medizinisches Cannabis unter strengen Auflagen legal verschrieben werden, insbesondere für die Behandlung von Patienten, die schwer erkrankt sind oder als nicht mehr therapierbar gelten.
Bei den Cannabisprodukten muss zwischen verschreibungspflichtigem medizinischem Marihuana oder medizinischen Cannabisextrakten, Fertigarzneimitteln auf Cannabisbasis und cannabidolhaltigen Produkten (CBD) unterschieden werden.
Medizinisches Marihuana und Cannabisextrakte (im Folgenden "medizinisches Cannabis").
Bei dem in Deutschland auf ärztliche Verschreibung erhältlichen medizinischen Cannabis handelt es sich in der Regel um getrocknete Cannabisblüten oder Zubereitungen aus Cannabisblüten.
Werden solche Zubereitungen aus Cannabisblüten in den wesentlichen Herstellungsschritten in der Apotheke hergestellt, unterliegen sie nicht der Erlaubnispflicht nach § 21 Abs. 2 Nr. 1 Arzneimittelgesetz (im Folgenden AMG). In der Praxis handelt es sich bei diesen Produkten um Extrakte aus der Cannabisblüte oder Aufgüsse aus Blüten und Blättern.
Fertigarzneimittel auf Cannabisbasis
Seit 2011 sind Fertigarzneimittel auf Cannabisbasis in Deutschland als verschreibungspflichtige Arzneimittel verkehrsfähig.
Fertigarzneimittel im Sinne des § 4 Abs. 1 Satz 1 AMG sind Arzneimittel, die bereits alle Herstellungsschritte durchlaufen haben, bevor sie an Apotheken abgegeben werden. Sie bedürfen einer Zulassung, § 21 Abs. 1 AMG, bevor sie in den Verkehr gebracht werden können.
Das erste in Deutschland zugelassene Fertigarzneimittel auf Cannabisbasis war ein THC-haltiges Mundspray, das unter dem Handelsnamen Sativex® vertrieben wurde.
CBD-haltige Produkte
Neben medizinischem Cannabis im engeren Sinne gibt es auf dem deutschen Markt auch verschiedene CBD-haltige Produkte. Diese Produkte fallen, sofern sie auf synthetischem CBD basieren, nicht unter das Betäubungsmittelgesetz (BtMG) und können in Deutschland ohne Einschränkungen verkauft werden.
Im Gegensatz dazu gibt es keine Rechtsprechung zur Verkehrsfähigkeit von Produkten, die auf natürlich gewonnenem CBD basieren. Das Bundesamt für Arzneimittel (BfArM) schließt die Anwendbarkeit des BtMG auf solche Produkte nicht aus. Vor diesem Hintergrund gibt es in Deutschland keinen verlässlichen legalen Vertrieb solcher Produkte.
Wie ist der rechtliche Rahmen?
Nach deutschem Recht ist Cannabis sowohl ein Betäubungsmittel als auch - unter strengen Voraussetzungen - ein Medizinprodukt. Aufgrund dieser doppelten Eigenschaft gilt das BtMG sowohl für verkehrsfähiges/legales (medizinisches) Cannabis als auch für nicht verkehrsfähiges/illegales Cannabis (Betäubungsmittel).
Was sind die Voraussetzungen für den Anbau und die Herstellung von medizinischem Cannabis?
Mit der "Legalisierung" von medizinischem Cannabis wurde beim BfArM die Cannabisagentur gegründet. Diese Agentur ist für den kontrollierten Anbau, die Ernte, die Verarbeitung, die Qualitätsprüfung, die Lagerung, die Verpackung und die Abgabe an Apotheken von medizinischen Cannabisblüten in Deutschland zuständig. [1]
Anbau, Ernte und Lagerung des Cannabis werden von Unternehmen durchgeführt, die in einem Vergabeverfahren ausgewählt werden. Alternativ kann die Lagerung auch durch einen vom BfArM zugelassenen Logistikdienstleister erfolgen.
Die Vorauswahl der Anbauunternehmen erfolgte gemäß § 19 Abs. 2a BtMG in einem europaweiten Vergabeverfahren, das im April und Mai 2019 mit der Vergabe an drei Unternehmen endete. Bei den beauftragten Unternehmen handelt es sich um die kanadischen Unternehmen Aphria und Aurora sowie den deutschen Cannabisproduzenten Demecan GmbH.
Um die Qualität des angebauten medizinischen Cannabis zu gewährleisten, gibt es Vorgaben nach der "Good Agricultural and Collection Practice (GACP)". Good Manufacturing Practice (GMP)" und der "Monografie `Cannabisblüten' (Cannabisblüten-Monografie)".
Die ausgewählten Unternehmen dürfen über einen Zeitraum von vier Jahren jährlich insgesamt 2.600 kg anbauen, ernten und verarbeiten. Die jährliche Gesamtmenge wird wie folgt auf die Produzenten aufgeteilt.
- Aphria (1.000 kg p.a.)
- Aurora (1.000 kg p.a.)
- Demecan GmbH (600 kg p.a.)
Die erste Ernte fand im Jahr 2021 statt, ein Jahr später als geplant. Außerdem konnten nur 50 kg geerntet werden.
Es ist also nicht möglich, den Bedarf an medizinischem Cannabis ausschließlich aus deutschem Anbau zu decken. Der darüber hinausgehende Bedarf wird durch Importe, vor allem aus den Niederlanden und Kanada, gedeckt. Im Jahr 2021 wurden rund 21.000 kg medizinisches Cannabis aus dem Ausland nach Deutschland eingeführt.[4]
Gibt es Einfuhrbeschränkungen für medizinisches Cannabis?
Für die Einfuhr von medizinischem Cannabis nach Deutschland ist die Bundesopiumstelle zuständig, die ebenfalls dem BfArM angegliedert ist. Wenn ein Unternehmen beabsichtigt, Cannabis für medizinische Zwecke einzuführen, benötigt es die folgenden Genehmigungen:
Erlaubnis zum Inverkehrbringen von Cannabis (§ 3 BtMG):
Das Inverkehrbringen von Cannabis, das auch die Ein- und Ausfuhr umfasst, bedarf einer Erlaubnis nach § 3 BtMG. Hierfür muss das interessierte Unternehmen einen Erlaubnisantrag bei der Bundesopiumstelle stellen unter:
Bundesinstitut für Arzneimittel und Medizinprodukte
Bundesopiumstelle
Kurt-Georg-Kiesinger-Allee 3
53175 Bonn.
Dieser ist für jeden an der Einfuhr/Ausfuhr beteiligten Arbeitnehmer in zweifacher Ausfertigung vorzulegen und muss folgende Angaben enthalten:
den vollständigen Namen oder die Firmenbezeichnung des Antragstellers,
eine Anschrift,
den Nachweis der erforderlichen Sachkunde,
eine möglichst genaue Beschreibung der Betriebsstätte,
die Sicherung der Produktionsstätten,
die beabsichtigte Einfuhrmenge und
das Produktionsverfahren.
Die Entscheidung über einen Genehmigungsantrag wird in der Regel innerhalb von drei Monaten getroffen.
Einfuhr-/Ausfuhrgenehmigung (§ 11 Abs. 1 BtMG):
neben der Vermarktungserlaubnis nach § 3 BtMG benötigen importierende Cannabisunternehmen auch eine Einfuhrerlaubnis nach § 11 Abs. 1 BtMG. Dabei handelt es sich um eine Einzelgenehmigung für die Einfuhr einer bestimmten Charge.
Für die Import-/Exportgenehmigung stellt die Bundesopiumstelle den Antragstellern unter BfArM - Import und Export Musterformulare in englischer Sprache zur Verfügung.
Grundsätzlich hat der Inhaber einer Erlaubnis nach § 3 BtMG einen Anspruch auf die Einfuhrerlaubnis. Diese darf nur versagt werden, wenn er bei der Antragstellung die Formalitäten nicht beachtet oder einer der Ausschlussgründe nach § 5 Abs. 1 BtMG vorliegt.
Hier sind insbesondere zu nennen:
- die mangelnde Sachkunde der für die Einhaltung der betäubungsmittelrechtlichen Vorschriften und der Anordnung der Überwachungsbehörden verantwortlichen Person (im Folgenden "verantwortliche Person"),
- Zweifel an der Zuverlässigkeit der verantwortlichen Person, des Antragstellers oder der zur gesetzlichen Vertretung oder Geschäftsführung befugten Person, sowie
- Fehlen geeigneter Räumlichkeiten, Einrichtungen und Sicherheitsvorkehrungen für die Teilnahme am Betäubungsmittelverkehr oder an der Betäubungsmittelherstellung
Vermarktung:
Die Werbung für Arzneimittel, Medizinprodukte und andere Mittel, Verfahren und Behandlungen, die der Linderung von Krankheiten und Beschwerden dienen, ist in Deutschland durch das Heilmittelwerbegesetz (HWG) geregelt.
Nach § 1 HWG und dem BtMG gelten hier besondere Regeln. Für verschreibungspflichtige Betäubungsmittel darf nur innerhalb der Fachkreise, d.h. insbesondere gegenüber Ärzten und Apothekern, geworben werden. Dabei müssen bestimmte, relativ detaillierte Pflichtangaben zur Zusammensetzung gemacht werden.
Alle Produkte, die für medizinische Zwecke bestimmt sind, unterliegen ebenfalls den Vorschriften für die Werbung für Arzneimittel. Cannabisblüten zum Beispiel dürfen ebenfalls nur in den (hier "eingeschränkten") Fachkreisen als Arzneimittel beworben werden. Für die Werbung mit wissenschaftlichen Studien gibt es weitere besondere Anforderungen. Bestimmte Werbemaßnahmen (wie Gewinnspiele oder die kostenlose Verteilung von Proben) sind auch gegenüber Patienten unzulässig. Werbung gegenüber Kindern ist überhaupt nicht erlaubt. Und schließlich ist es nicht erlaubt, mit potenziell beeinflussenden Inhalten zu werben: Die Wiedergabe von Krankengeschichten, entsprechenden Bildern oder Zitaten von Patienten ist ebenso unzulässig wie Aussagen über die Wirksamkeit im Vergleich zu anderen Produkten oder eine (vermeintliche) Verbesserung der Gesundheit. Generell darf bei den Adressaten der Werbung keine Fehlvorstellung erzeugt werden: Irreführende Werbung ist auch bei Heilmitteln verboten.
Verstöße können strafrechtlich, aber auch mit Bußgeldern (gegen das Unternehmen) geahndet werden. Darüber hinaus können Wettbewerber und Verbände zivilrechtlich die Unterlassung solcher Werbung verlangen.
Erwerb von medizinischem Cannabis (Krankenhäuser, Ärzte oder Patienten)
Medizinisches Cannabis ist in Deutschland nicht frei verkäuflich. Vielmehr darf es nach § 1 Abs. 2 der Betäubungsmittel-Verschreibungsverordnung (BtMVV) nur an Patienten abgegeben werden, die eine ärztliche Verschreibung für Betäubungsmittel haben. Es wird in der Regel in öffentlichen Apotheken abgegeben.
Berechtigung zur Verschreibung
Nach § 1 Abs. 1 lit. a) BtMVV darf der Arzt seinen Patienten innerhalb von 30 Tagen eine Höchstmenge von 100.000 mg Cannabis in Form von getrockneten Blüten oder 1.000 mg Cannabisextrakt (bezogen auf den Δ9-Tetrahydrocannabinol-Gehalt) verschreiben. Nach Abs. 2 darf eine über diese Höchstmenge hinausgehende Verschreibung nur in begründeten Einzelfällen ausgestellt werden.
Ein begründeter Einzelfall liegt vor, wenn die vorgesehene Höchstmenge nicht ausreicht, um die gewünschte, schmerzlindernde Wirkung zu erzielen und sich der Patient in einer Langzeitbehandlung durch den verordnenden Arzt befindet.
Zahnärzte und Tierärzte dürfen medizinischen Cannabis nach § 3 Abs. 1 lit. b) und § 4 nicht verschreiben. 1 lit. b) und § 4 Abs.. 1 lit. b) BtMVV.
Voraussetzungen für die Verschreibung von medizinischem Cannabis:
Patientinnen und Patienten haben einen Anspruch auf Kostenerstattung für die Behandlung mit medizinischem Cannabis, wenn die folgenden Voraussetzungen des § 31 Abs. 6 SGB V vorliegen:
Das Vorliegen einer schweren Erkrankung,
die fehlende Verfügbarkeit einer Standardtherapie oder die begründete Einschätzung des behandelnden Arztes,
eine nicht ganz fern liegende Aussicht auf eine spürbare positive Wirkung auf den Krankheitsverlauf oder auf schwere Symptome und
die Zustimmung der Krankenkasse des Patienten
Unter welchen Voraussetzungen eine schwere Krankheit angenommen wird, hängt vom Einzelfall ab, wird aber in der Regel angenommen, wenn sie lebensbedrohlich ist oder die Lebensqualität nachhaltig (mindestens sechs Monate) beeinträchtigt. Mögliche Beispiele sind Multiple Sklerose, schwere Krebserkrankungen, schwere Schlafstörungen im Rahmen des Restless-Leg-Syndroms und posttraumatische Belastungsstörungen (PTSD).
Welche Entwicklungen sind innerhalb des rechtlichen Rahmens in Ihrem Land zu erwarten?
Die rechtlichen Rahmenbedingungen für medizinisches Cannabis in Deutschland, aber auch für Cannabis als Genussmittel, befinden sich derzeit im Wandel.
Ein wichtiger Schritt zur Liberalisierung des Cannabismarktes ist der im August 2023 vorgelegte Gesetzentwurf der Bundesregierung, der zwischen Cannabis für Freizeitzwecke und medizinischem Cannabis unterscheidet.
Für medizinisches Cannabis enthält er die entscheidende Regelung, dass erstmals ein eigenständiger Rechtsrahmen für medizinisches Cannabis, gebündelt in einem Gesetz, geschaffen werden soll. Zu diesem Zweck soll das so genannte Medizinal-Cannabisgesetz (im Folgenden MedCanG) eingeführt werden.
Da sich die bisherigen Regelungen im BtMG aus Sicht des deutschen Gesetzgebers bewährt haben, sind diese weitgehend in den Entwurf des MedCanG übernommen worden. Anbau, Ernte und Lagerung von medizinischem Cannabis dürfen weiterhin ausschließlich von Unternehmen durchgeführt werden, die in einem europaweiten Vergabeverfahren ausgewählt wurden (siehe Abschnitt B).
Das MedCanG sieht kleinere Erleichterungen für Arztpraxen und Apotheken vor. Der bürokratische Aufwand soll dadurch verringert werden, dass Verschreibungen nicht mehr auf BtM-Rezepten erfolgen müssen. Außerdem müssen die Apotheken die Abgabe von medizinischem Cannabis nicht mehr dokumentieren.
Gibt es finanzielle Vorteile (staatliche Beihilfen, Steuervorteile usw.), um die medizinische Cannabisbranche zu fördern?
Die deutsche Regierung gewährt Unternehmen keine oder keine direkten finanziellen Anreize für den Anbau von medizinischem Cannabis.
Die Verpflichtung, die Genehmigung für den Anbau von medizinischem Cannabis auszuschreiben, führt auch dazu, dass die Unternehmen, die den Zuschlag erhalten, vor Wettbewerb geschützt werden.
Gibt es innerhalb des Rahmens für medizinisches Cannabis in Ihrem Land Möglichkeiten oder Spielraum für Unternehmer im weiteren Ökosystem (z. B. Informationsaustausch zwischen Ärzten oder Patienten)?
Für den Austausch von Informationen über die Therapie mit medizinischem Cannabis müssen die Datenschutzbestimmungen im medizinischen Bereich eingehalten werden.
Aus kartellrechtlicher Sicht ist ein Austausch von Informationen zwischen Ärzten über medizinische - letztlich rein fachliche - Anamnesen und Therapien unproblematisch.
Gibt es in Ihrem Bereich spezielle Anforderungen, Regeln oder Verfahren, die befolgt werden müssen, die in anderen Rechtsordnungen nicht gelten?
Abgesehen von den oben genannten Vorschriften gibt es keine besonderen, nationalen Anforderungen oder Verfahren für den Vertrieb oder die unternehmerische Tätigkeit im Zusammenhang mit medizinischem Cannabis.

Melden Sie sich hier zu unserem GvW Newsletter an - und wir halten Sie über die aktuellen Rechtsentwicklungen informiert!